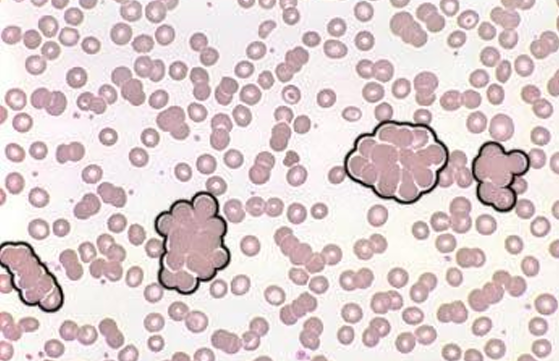
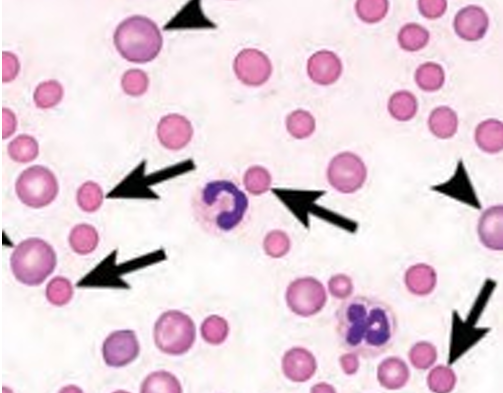
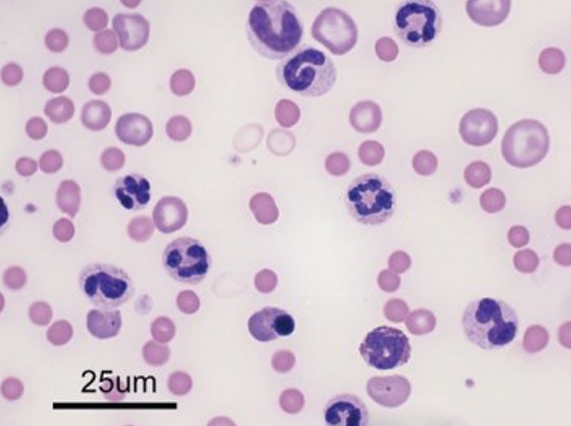

Common Immune-Mediated Disease
1) Immune-Mediated Hemolytic Anemia (면역 매개성 용혈성 빈혈)
Etiology
- 면역매개 기전에 의한 RBC의 급격한 파괴로 발생한 빈혈 (이름 그대로 면역 매개 + 용혈로 RBC 파괴 + 빈혈)
- 개의 용혈성 빈혈 중 가장 흔한 원인
- 고양이에서는 흔하지 않음.
Primary IMHA
- RBC 막의 항원(막단백질)에 항체가 direct로 결합함.
- 어떤 단백질이라고 명확하게 구분되진 않았고, 확인된 건 spectrin, band 3, glycophorins 등
- Secondary form보다 primary form이 더 흔함. (secondary 원인을 rule-out해서 진단)
- 개와 고양이의 RBC에서 IgG > IgM > IgA 순으로 확인. + 보체가 매개하기도 함.
- SLE의 징후일 수도 있음.
Secondary IMHA
- 감염, 종양
- 약물 노출, 독소 + 백신의 가능성도 있음.
- 대표적인 원발 원인
- 개 : Dirofilariasis(개사상충), Babesiosis + Hemotrophic mycoplasmosis, Leishmaniasis, Ehrlichia canis infection, Anaplasma phagocytophilum infection 등
- 고양이 : Hemotrophic mycoplasmosis + Feline infectious peritonitis, leukemia virus 등
-
백신? 2-4주 이내 백신을 맞은 그룹의 발병률이 더 높았던 연구가 있으나, 명확한 근거 X
-
Genetic predisposition
- Cocker Spaniel에서 가장 호발 (1/3 수준, ‘Dog erythrocyte antigen 7’ 때문이라고 예상하나, ?)
- Bichon Frise, Miniature Pinscher, Miniature Schnauzer + Finnish Spitz, English Springer Spaniel, Rough-coated Collie 등에서도 잘 나타남.
-
RBC에 붙은 항체/보체는 Intravascular or extravascular Hemolysis를 일으킬 수 있음.
| 혈관외 용혈_ | Extravascular Hemolysis |
|---|---|
| 특징 | - 간, 비장, 골수의 Mononuclear-phagocytic system(MPS)에 의해 RBC가 탐지되어 phagocytosis됨. - 혈관내용혈보다 더 흔하고, 덜 심각하다. - spherocytosis, hyperbilirubinemia 와 동반된다. |
| 발생 | - Phagocytosis의 stimuli : (1) intracellular inclusions (RBC parasites, Heinz bodies) : (2) IgG나 IgM으로 코팅된 membrane (개에서 주로 원인) - 선천적으로 발생할 수도 있음 : RBC 자체 효소 문제 (Congenital RBC enzymopathies) |
과정 | (1) 적혈구가 탐식됨 : 비정상 RBCs 인식 → MPS에 의해 phagocytosis → circulating RBC 수 감소 & spherocytes 증가 (2) lysosome 안에서 hemoglobin으로 분해되어, 철과 biliverdin으로 분해됨 (3) bilirubin으로 전환되고, 간에서 대사됨. - 따라서 Hyperbilirubinemia는 발생할 수 있는 반면, 혈류에 순환하는 hemoglobin이 다 분해되었기 때문에 Hemoglobinuria, hemoglobinemia는 발생하지 않는다. - 일반적으로 IgG에 의해 매개된다. |
| 혈관내 용혈 | Intravascular Hemolysis |
|---|---|
| 특징 | - RBC의 direct lysis → 혈관 내를 순환하던 적혈구가 shear stress, toxin, complement 등에 의해 lysis됨. - 혈관외용혈보다 덜 흔하지만, 예후가 더 불량하다. - secondary로 많이 발생 : 개의 DIC with 혈관육종(HSA; hemangiosarcoma), 아연 독성, 저인혈증(hypophosphatemia) - 특정 congenital enzymopathy일 수도 있음 : 개의 PFK(phosphofructokinase) deficiency |
| 발생 | Caused by.. - 보체를 활성화시키는 항체 - 감염체 (ex - Babesia canis) - 약물, 독성 (ex - 동전의 아연, 이동장의 나사, zinc-containing ointments 등) - 대사적 불균형 (ex - 당뇨로 인슐린 처방 중일 때 hypophosphatemia) - RBC의 shearing(미는 힘) 증가 (ex - DIC, microangiopathy) |
과정 | (1) 혈관 내에서 혈장 hemoglobin 유리 (2) Haptoglobin + hemoglobin 결합하여 간에서 제거됨. (3) Hemoglobin이 haptoglobin보다 넘치면, 신장세뇨관으로 배설되어 hemoglobinuria 발생. |
Spherocytes (구상적혈구)
- 항체로 코팅된 적혈구막 일부가 탐식되어, 크기가 작아지고 창백한 중앙부가 소실된 적혈구 형태
⇒ loss of the normal discoid shape, decreased size, loss of central pallor- 과정 : Mononuclear-phagocytic cells가 적혈구의 항원에 부착, Fc receptor와 결합 → 세포질과 막이 뜯겨짐(“bites off”) → 남은 애들끼리 뭉쳐서 더 작고, central pallor가 없는 spherocyte 형성
- 면역 용혈 빈혈뿐만 아니라 Babesia gibsoni 감염, 아연 독성, hemophagocytic malignant histiocytosis, 보관한 지 오래된 피를 수혈했을 때도 나타날 수 있는 특징.
- 개 : 주로 immune hemolysis에 의해
- 고양이: 면역보다는 Drug-associated hemolysis(β-lactam 항생제 잘못 먹었을 때), mycoplasmosis + IHA 등에 의해 나타날 때가 많음
- 정상 적혈구보다 단단(more rigid), 잘 변형되지 않음(less deformable), 비장을 통과하면서 제거됨.
그 외. 용혈성 빈혈의 원인

Clinical features
- 어리거나 중년 개체에서 호발. 1-13세, 평균 연령 6세에서 관찰됨.
- 암컷, 중성화 수컷 > 중성화X 수컷 (intact male)
| 임상 증상 | 신체 검사 |
|---|---|
| lethargy (기력저하) | systolic heart murmur (심잡음) |
| anorexia (식욕부진) | pyrexia (열) |
| pallor (창백) | pallor (창백) |
| icterus (황달) | icterus (황달) |
| vomiting (구토) | tachycardia (빈맥; 빈혈에 대해 보상성) |
| collapse (허탈; 갑자기 쓰러짐) | tachypnea (빈호흡; 빈혈에 대해 보상성) |
| weakness (허약; 쇠약한 걸음, 상태) | splenomegaly (비장종대) |
| hepatomegaly (간종대) | |
| abdominal pain (복부 통증) |
- 고양이에서 추가로 나타나는 소견 : 심잡음, 열, 창백, 황달, hypothermia, lymphadenomegaly
- 임상 증상의 기간 : 짧은 편, 평균 4-5일.
- 따뜻한 계절에 발생 증가 - 봄이면 확연히 IMHA 진단이 증가하는 편.
Diagnosis
- 면역 매개성 + 용혈성 + 빈혈 에 대한 확인 → 확진.
ACVIM IMHA consensus (2019)
- 2가지 이상의 면역 매개성 근거 : spherocyte, SAT 검사 양성, DAT 검사 양성
- 1가지 이상의 용혈 근거 : Hyperbilirubinemia, bilirubinuria, 황달 등
- 혈관내용혈 → hemoglobiemia, hemoglobinuria,
1) Anemia 확인
- 빈혈 = 적혈구가 부족한 상태.
- 그 원인으로는
- Hemorrahge - 출혈 (적혈구 손실)
- Hemolysis - 용혈 (적혈구가 체내에서 탐식, decreased lifespan)
- Decreased production - 적혈구 생성 이상 (골수 or 골수외 이상)
IMHA에서
- Moderate ~ marked anemia (중등도 ~ 두드러진; 평균 PCV 13%)
- 주로 재생성(regenerative) 빈혈 / 개에서 30%, 고양이에서 50% 이상 비재생성(nonregenerative).
- 왜 비재생성으로 나타나는가?
- (1) 골수가 빈혈에 반응하여 재생성이 생기기 전이거나 (3-5일 소요)
- (2) 골수의 전구체에 항체가 생겨, reticulocytes들이 말초 순환으로 나가기 전 이미 파괴
- CBC상 Inflammatory leukogram 나타날 수 있음. (호중구와 단핵구 증가, 림프구와 호산구 감소, 미성숙 세포가 증가하는 핵좌방이동 동반)
- 60%에서 mild~severe thrombocytopenia
- 혈소판과 적혈구 모두에서 항체가 생기는 Evans syndrome일 때, IMHA로 인해 DIC 발생했을 때, 혈소판이 비장에 격리되었을 때(splenic sequestration - very rare)
CBC에서 보일 수 있는 소견
- Anemia
- Polychromasia (다염색성; 미성숙적혈구가 말초로 많이 나와 염색상이 다양)
- Autoagglutination
- Spherocytosis
- Ghost cells
- Evidence of inflammation (increased neutrophils, bands, metamyelocytes, monocytes)
- Thrombocytopenia
Biochemical profile에서 보일 수 있는 소견
- Hemoglobinemia / -uria
- Hyperbilirubinemia / -uria
- Increased alanine aminotransferase
- Increased akaline phosphatase
(혈중, 요중의 헤모글로빈, 빌리루빈, 간효소 수치 상승)
2) Immune-mediated 확인
- Autoagglutination or Spherocytosis : 항체가 매개하는 적혈구 용혈의 직접적인 증거
| 검사법 | |
|---|---|
| Autoagglutination test Macroscopic, microscopic examination | - 자가응집 있는지 육안 확인 - EDTA 튜브에서 미세한 점들이 튜브 벽에 붙는 양상 - 슬라이드에 혈액 drop → 적혈구가 뭉치는 현상 (* 생리식염수로 해소해서 Rouleaux(염전)과 구분!) |
| Spherocytes - 크기가 작음 - central pallor 없음 | - 개에서는 쉽게 식별 가능하나, 고양이에서는 어려움(정상 적혈구도 central pallor 없음) - Hallmark morphologic change : 90% 이상의 IMHA dogs에서 관찰됨. * 1000배 시야에서 11-50개의 spherocyte → 진단 기준상 2 positive로 취급 - 다른 질병에서도 낮은 수의 spherocyte는 관찰 가능 (아연 독성 용혈, 혈구탐식 증후군) - 극도로 빠른 용혈에서는 적게 나타날 수 있음. |
| Direct Coombs test (DAT 검사) | - autoagglutination, spherocytosis 관찰되지 않을 때 실시 - ‘RBC 막에 항체나 보체가 있는 것’을 의미 - ‘RBC 막에 대해 용혈을 유발하고 있다’를 의미하지 않음. ⇒ IMHA의 확진에 민감(sensitive)하거나, 특이(specific)하지 않음. - 60-80% 환자에서 양성 결과가 나타나지만, 위양성/위음성을 주의해야. * 사람에서는 4℃에서도 실시 (cold agglutination test) - 개에서는 확인된 바 없음. |
Secondary cause of IMHA
- 기저 질환을 찾는 것은 관리와 예후를 위해 중요하다.
DDx for secondary IMHA
3) 용혈성 확인 (RBC 검사)
골수 검사
-
비재생성 빈혈에서 다음 소견들이 관찰됨
- Erythroid hyperplasia + low M/E ratio
- rubricyte나 metarubricyte stage에 maturation arrest
-
IMHA 의심 환자가 골수 검사 결과 PRCA로 진단되기도 함.
-
myelofibrosis(골수 섬유증)가 있으면
- 골수 흡인이 어려워 적절한 골수 성분을 수집하기 어려움.
- 골수 손상에 대한 2차적인 반응. 치료에 반응하면 대부분 호전됨.
-
IMHA 환자의 전형적인 morphologic change : regnerative anemia, autoagglutination, spherocytes
- 이 sign들이 확인되지 않으면 진단 쉽지 않음.
-
Coombs test 양성 결과는 위양성 가능성을 고려해서 주의깊게 해석되어야 함.
🩸 Blood smear
(따로 정리 못함, 그러나 여기도 중요한 내용)
Treatment
IMHA의 치료 결정이 쉽지 않은 이유
- 연구 근거 부족 (전형적 연구 < 후향적 연구 → 경험적 데이터만 많음)
- 예후가 좋지 않음
- 치료에 비용이 많이 듦 (처음 발생 시 수혈+약물 치료 → 비쌈, 효과는 좋음. / 재발하면 예후도 안 좋음,,)
- 심각한 합병증이 종종 발생 (Pulmonary thromboembolism, DIC)
⇒ 주치의의 주관적인 판단에 의존할 때가 많음.
- 치료는 1) 용혈 방지(erythrophagocytosis를 저해), 2) 면역 반응 저해 (항체, 보체가 적혈구에 붙지 않도록)
1) Hemolysis 예방 - Immunosuppressive drugs
이 부분은 2단원과 아주 많이 겹쳐서, 핵심 내용+새로운 내용 위주로 간단히 정리하겠음.
Glucocorticoids
- first line, 경구 투여, 2.2mg/kg 정도
- 처음에는 고용량으로 투여하여 치료 효과를 낸 뒤, 점차 감소
- 단 대형견(> 30kg, 넉넉하게 15-20kg 이상) 에서는 민감하므로 주의.
- 체표면적 기준 투여가 좋음. (mg/m2)
- 치료 효과가 빠른 편이지만, full 치료에는 4주 정도 걸리니, 천천히 치료반응 기다리기.
- 치료 효과 확인은..
- hematocrit 증가 / Coombs 결과가 음성이었는데 음성으로 바뀜 / 자가응집 해소, spherocyosis 개선, reticulocyte 정상 수준으로 회복 / 염증 상태 개선
- Hematocrit > 30%면 잘 회복되고 있다는 의미 (정상 범위는 35-55% 정도)
- 1달에 2-30%씩 3-6개월간 tapering (HCT, 부작용 잘 살피며)
- 6개월 정도 지나면 격일 복용 (PDS, azathioprine)
- 다 나으면 단약 시도
- 빠르게 감량하면 재발 위험 높으니 천천히, 개체 차이 고려!
- 치료반응 전후 2주씩 CBC, reticulocyte count 꼬박꼬박 체크하기
2nd 면역억제제 고려
- Glucocorticoid 약이 잘 듣지 않거나, 기대만큼 효과가 없거나, 부작용이 너무 심할 때.
- 빠르게 적용하는 게 나을지, 조금 기다려보는 게 좋을지는 명확하지 않음.
- 장점) 빠른 치료, 반응이 나타나기까지 2-4주 걸리므로 미리 투약해야 제때 효과
- 단점) 감염 취약, 치료의 이익이 불분명함. 가이드라인 부족.
- 이것도 정해진 용량에서 투여 시작하기
- 2nd 면역억제제 유지하면서 steroid 먼저 감량하고 → steroid 단약 후 면역억제제 감량도 고려해보면 됨. (다만, 면역억제제도 반드시 tapering 해야 하는가?에 대한 합의 X)
INDICATIONS?
- gluticorticoid 투여 5-7일 내에 반응이 없을 때
- 수혈이 2번 이상 필요할 때
- glucocorticoid 부작용을 견디기 힘들 때(특히 대형견)
- 불량한 예후 인자 (혈관내용혈, 심각한 황달, 자가응집 지속, Evans syndrome 등)
- Acute하게 진행될 때 (24시간 이내 PCV 5% 이상 감소)
| 약물 | |
|---|---|
| (1) Azathioprine | - 치료 효과나 생존 기간 개선에 대한 통계적 근거 없음. - 골수 억압, 간독성 부작용 주의 → CBC & hepatic enzymes 더 정기적으로! - 하루 1번 투여로 시작 → 점차 격일 복용으로 감량(EOD; every other day) |
| (2) Cyclosporine | - perianal pistula 등에도 많이 쓰임. - 조금 더 비쌈, 면역억제 효과 좋아서 감염 모니터링 필요. - cyclophilin과 결합해서 IL이 일으키는 면역반응을 차단함. - IL-2 억제에 특히 효과. IMHA 환자 중 IL-2 많이 증가한 환자에 사용 - PDS, azathioprine에 효과 없는 개에서 좋은 대체 약물. (더 안전, 효과적) |
| (3) MMF | - Azathioprine의 부작용을 줄여, 가장 최근에 개발된 신약. - dose-dependent한 위장관 독성 (용량 잘 지키면 됨) - 외국에서는 주사 제제로 사용 가능 |
| (4) hIVIG | - IMHA 효과 있는지 근거는 매우 부족함 - 매우 비싼 편이나, 급할 때 구제 약물로 단기간 사용. |
| 기타 | - Leflunomide : 사람에서는 류마티스 관절염에 효과, 개에서는 broad하게 사용. 그러나 IMHA에서는 Aza, Cyclo, MMF를 우선으로 사용하는 편. - Cyclophosphamide ⛔ : IMHA에서 효과가 전혀 없다고 밝혀진 유일한 약물. - 효과 없을 시 비장 절제술(splenectomy)도 고려 |
2) Blood Transfusion (수혈)
- 급성의 심각한 IMHA에서는 산소를 운반할 적혈구가 없기 때문에 산소 공급 & 수혈 필요.
- 산소 공급 단독으로는 효과가 제한적.
- 중증도나 급성or만성 / 병발 질환의 여부와 정도 (pulmonary thromboembolism, GI 출혈) 고려하여 결정.
- 안정 시 명백한 빈혈 증상 (Tachycardia, tachypnea, anorexia, lethargy, weakness) 있을 때만 권고됨.
- acute IMHA + PCV <15% → 조직 저산소증(hypoxia) 있으므로 수혈 권장!
- 그러나 절대적인 수치는 없고 반드시 개별적으로 고려.
- packed RBCs가 이상적 - 혈장 성분은 필요하지 않고, 부작용 위험이 증가함.
- but 상황에 따라 혈장도 같이 넣어주는 게 (전혈을 넣어주는 게) 좋을 수도 있음. → 심한 출혈, 혈장 단백질 부족, 탈수, 응고인자 부족 등의 상황
3) Thromboembolism(혈전) 예방
- TEG(thromboelastrography) 으로 측정.
- IMHA는대표적으로 과응고 유발 / 혈소판(혈액 응고) 자체가 적으면 IMHA여도 저응고 나올 수 있음.
- 혈전(TEs; Thromboembolic events)은 29-100%까지 발생, 폐사의 주요 원인.
- 카테터 장착 → 혈전 위험을 높임.
- thrombocytopenia, hyperbilirubinemia, leukocytosis, hypoalbuminemia : 혈전 위험 증가.
- 혈전이 나타나는 과정이나, 혈전 예방에 효과적인 약물은 밝혀진 바 없음.
혈전예방 약물
- 혈소판감소증이 심각할 때는 thromboprophylaxis(혈전예방) 보류. : platelet <30000/μL
- 혈액 응고 안 되는 상황에서, 항혈전제까지 넣으면 더 악화
- heparin, low-molecular-weight heparin, aspirin, clopidogrel 혹은 이들의 조합.
- Heparin : anti-Xa 활성, aPTT 측정해 가며 조절해서 투여하면 더 예후 좋음. (현실적으로 쉽지 않음)
- Low-molecular-weight heparin (LMWH) : SC로 투여, Dalteparin, Enoxaparin.
- Low-dose aspirin (0.5mg/kg) : PDS+azathioprine+low-dose aspirin 많이썼음.
- 지금은 clopidogrel, rivaroxaban 등 더 좋은 약물이 나옴.
- Clopidogrel bisulfate : 항혈소판제, 고양이 비대성 심근병증에서 생기는 혈전에서 gold standard.
- 고양이 비대성 심근병증(HCM, hyperchlomyopathy) ⇒ FATE (Feline Arterial Thromboembolism)
- HCM으로 혈전 생기면 마비되고 피가 안 통해 다리를 절 수 있음.
- Rivaroxaban : Xa inhibitor를 경구 투여. 퇴원 시 주기 좋은 약물. (Xa → 자렐토)
4) Supportive care
Fluid therapy
- 탈수의 증거가 명확할 때 조직 관류개선을 위해 수혈 + fluid therapy 이용 가능.
- 탈수 개에서 수액 치료 → hematocrit 감소 but total RBC mass에는 변화 없음.
- 탈수 교정 하면 PCV가 떨어지는 게 정상, 그러나 그게 진짜 PCV니까 거기 맞춰서 치료 및 예후 평가 하는 게 맞음.
Underlying disease
- 기저 질환 있으면, 원발 원인 치료가 우선.
- 필요한 경우 면역억제제 사용할 수는 있으나, 기저질환 치료가 더 중요함.
- 감염성 질환일 경우 steroid, 면역억제제 사용 주의.
면역억제제 조합
- 골수 억압, 감염 위험, GI 궤양과 출혈, iatrogenic hyperadrenocorticism(쿠싱) 위험 → 부작용 잘 대비해서 정말 단기간 사용!
- 위장관출혈의 예방을 위해 sucralfate / famotidine(H2 blocker) / omeprazole (proton pump inhibitor) 사용
Prognosis
- primary IMHA의 치사율 : 26~70% (그 중 30-60%는 혈전으로 사망)
- 혹은 면역억제제로 인한 감염, 빈혈 조절 실패, DIC → 산소 공급 부족, 다발성 장기 손상으로 사망
- 혈소판 소모성이 있는 질환이라, 과응고 상태에서 오히려 예후가 좋을 수도?
- major thromboembolism → 극도로 예후 불량
| GOOD prognosis |
|---|
| - PDS 치료 반응 좋을 때 - PCV 30% 이상으로 잘 유지될 때 - 기저질환의 치료가 쉬울 때 |
| BAD prognosis |
| - Steroid 반응성 없어 다른 약물 필요할 때 - 자가응집이 계속될 때 - 신장 기능이 감소하여 Azotemia가 나타날 때 - Bilirubin 농도가 높아질 때 (hyperbilirubinemia) - 혈소판 감소가 뚜렷할 (thrombocytopenia) - 염증이 심해 심각한 leukocytosis 있을 때 |
Feline IMHA
- secondary 비율이 더 높음.
- 어린 연령 (평균 2살 이하)에서 잘 걸림.
- 중성화 여부 상관없이 수컷에서 호발.
- 재생성/비재생성 빈혈 반반
- PDS 단독 치료의 반응이 괜찮은 편 → 당뇨 주의!
- chlorambucil 많이 씀, azathioprine은 사용 금지.
- Feline leukemia virus, Mycoplasma haemofelis : 흔한 원발 원인

